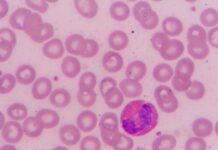
Riddoch, Lady Nelson to light up

Mount Gambier/Berrin to host 2026 Regional and Remote Music Summit
MUSICSA has announced the 2026 Regional and Remote Music Summit will take place in Mount Gambier/Berrin.
The 2026 event will be the third national...
Vale Vivien Alice Vanstone
By Ian Riley, Sharyn Taylor and Kerrie Davies
ONE year after her passing, Dr Vivien Vanstone, nematologist, mentor and friend to people from many parts...
State government matches federal funding in battle against algal bloom
The federal government's $14 million funding commitment to support the response to the Karenia mikimotoi algal bloom will be complemented by an equal contribution...
Burial fees to be waived
FAMILIES of still born babies and children up to the age of 10 will have some relief, with Naracoorte Lucindale Council overturning a decision...
Lepse is our young ambassador
GREENWAYS woman Shayla Lepse has done the South East proud, being named the South Australia Young Rural Ambassador.
Ms Lepse was awarded at the SA...
Concerns raised over council abuse
ABUSE and aggression towards the City of Mount Gambier councillors and council staff was the topic of a motion moved at this month’s city...
Speedway safety
THE Borderline Speedway safety fence will be replaced while the committee continues to seek government funding for further upgrades.
The current safety fence has...
SA Today expands with acquisition of iconic Lanyon newspapers
SA Today has continued its growth across regional Australia with the acquisition of five historic mastheads from the Lanyon family Mildura, marking a significant...
Riddoch, Lady Nelson to light up
Mount Gambier/Berrin's Riddoch Arts and Cultural Centre and the Lady Nelson will light up pink and purple to raise awareness during National Eosinophilic Week....
Nod of approval from visitors
MORE than 350 members of the public recently inspected Wattle Range Council's new service centre.
During last Sunday's open day event the community were able...